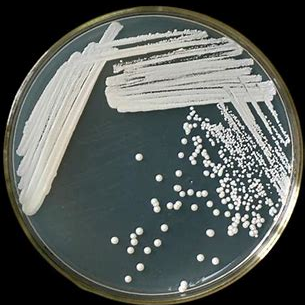

「Make the Earth Cool」
人人都是公民科学家

©️来源网络 酿酒酵母宏观和微观特征图
公民科学计划中国少数民族地区酿酒酵母收集与保护招募志愿者啦!
为什么要关注酿酒酵母资源?
酿酒酵母 Saccharomyces cerevisiae 在全世界均有分布,广泛存在于自然环境和人类社会中,它的驯养历史悠久,被称为“第一种家养微生物”,由于具有快速降解糖类物质产生 CO2 和乙醇的能力,被用来生产出了种类繁多的发酵食品,在人类文明发展过程中发挥了重要作用,尤其在我国少数民族地区被用来制作出各具特色的传统发酵食品,其中以酒类最为丰富。
比如壮族有水酒、砸酒、窑酒,维吾尔族有慕萨莱思,苗族和羌族有砸酒,彝族有泡缸酒、燕麦酒、苦荞酒、咂竿酒和刺梨酒,土家族有韵酒、砸酒、苞谷酒,藏族有青稞酒,蒙古族和哈萨克族有马奶酒,布依族有糖酒、糯米酒、刺梨酒,侗族有高粱酒、玉米酒、红薯酒、糯米酒,瑶族有玉米酒,哈尼族有闷锅酒、甜白酒,黎族、傣族和畲族有糯米酒,仡佬族有烧酒、甜酒、砸酒,水族有九阡酒,佤族和景颇族有水酒等。这些民族保存了古老的酿酒工艺和文化,具有悠久的历史,但如今面临着消失的风险,急需进行保护和传承。




©️来源网络 上图依次为马奶酒、青稞酒、糯米酒和刺梨酒
公民科学计划
招募项目介绍
公民科学是通过大众参与科研的基础调查等工作,为科研团队提供相对规范的调查数据及样本,助力科研。
■ 课题团队介绍

微生物研究所酵母与酿造微生物课题组组长:白逢彦 研究员、教授、博士生导师——国家杰出青年科学基金获得者,中科院百人计划人才入选者,国务院政府特殊津贴获得者,主要从事酵母菌资源、系统进化和酿造微生物组等方面的研究。
■ 志愿者招募时间
2023年1月—2025年12月
■ 志愿者招募要求
① 年满18周岁的在校本科生及研究生,或热心公益的社会各界人士;
② 专业不限,对本研究感兴趣;
③ 居住在少数民族地区的人,最好本人也是少数民族;
④ 需身心健康,认真仔细,吃苦耐劳,有责任心。
■ 志愿者工作内容
① 采集少数民族地区发酵环境样品(自制传统发酵食品:酒、馕等)和野生环境样品(原始森林、次生林、人工林和果园等中的树皮、树干渗出液、腐木、花果和土壤等),需标注样品类型、采集人姓名、采集时间和地点,并尽快邮寄,最好对采样环境进行拍照记录,其中重点是发酵样品的咂(砸)酒,如下图所示,也可以是酿酒用的酒曲,但均不能是购买的商业酒曲及其酿的酒;(可提供快递费、样品管和采样技术指导)


©️来源网络 咂酒



©️来源网络 酒曲
② 如有实地采样计划,到时候愿意做向导或提供其他帮助的也可以参与进来,未来将会去四川、云南、贵州等的少数民族地区进行调查采样。
■ 志愿者福利
① 加深对少数民族传统发酵食品及其文化的了解;
② 学习野外采样技术和提高对真菌(酵母)的认识;
③ 有机会结识其他民族的朋友;
④ 获得一定的劳务费和志愿者证书;
⑤ 如果特别感兴趣的相关专业学生,可以以此为基础协助申请大学生假期社会实践项目,甚至有可能到课题组进行参观学习以及毕业设计等。
■ 报名方式
扫描下面二维码,填写报名信息,并加入微信群。
如不符合上述要求但也想加入本次课题项目的,可咨询课题组工作人员——胡双 16601550388。

报名二维码

群二维码
其他联系方式:
工作邮箱:16601550388@163.com
通讯地址:北京市朝阳区中国科学院大学奥运村校区微生物研究所F座
组织机构
![]() | 中国科学院微生物研究所 中国科学院微生物研究所成立于1958年12月3日,由中国科学院应用真菌研究所和中国科学院北京微生物研究室合并而成,目前已发展成为一个具有雄厚研究基础和广泛影响力的微生物学研究和微生物技术研发机构。 |
![]() | 极地未来 Polar Hub 天津市极致应对气候变化促进中心 成立于2017年5月,是国内首个以科学探险、科学考察以及科普教育为主要方式,致力于气候变化应对,践行可持续发展的公益组织。 |
-THE END-
编辑:胡双、高瑞晶
校审:虎姣佼





